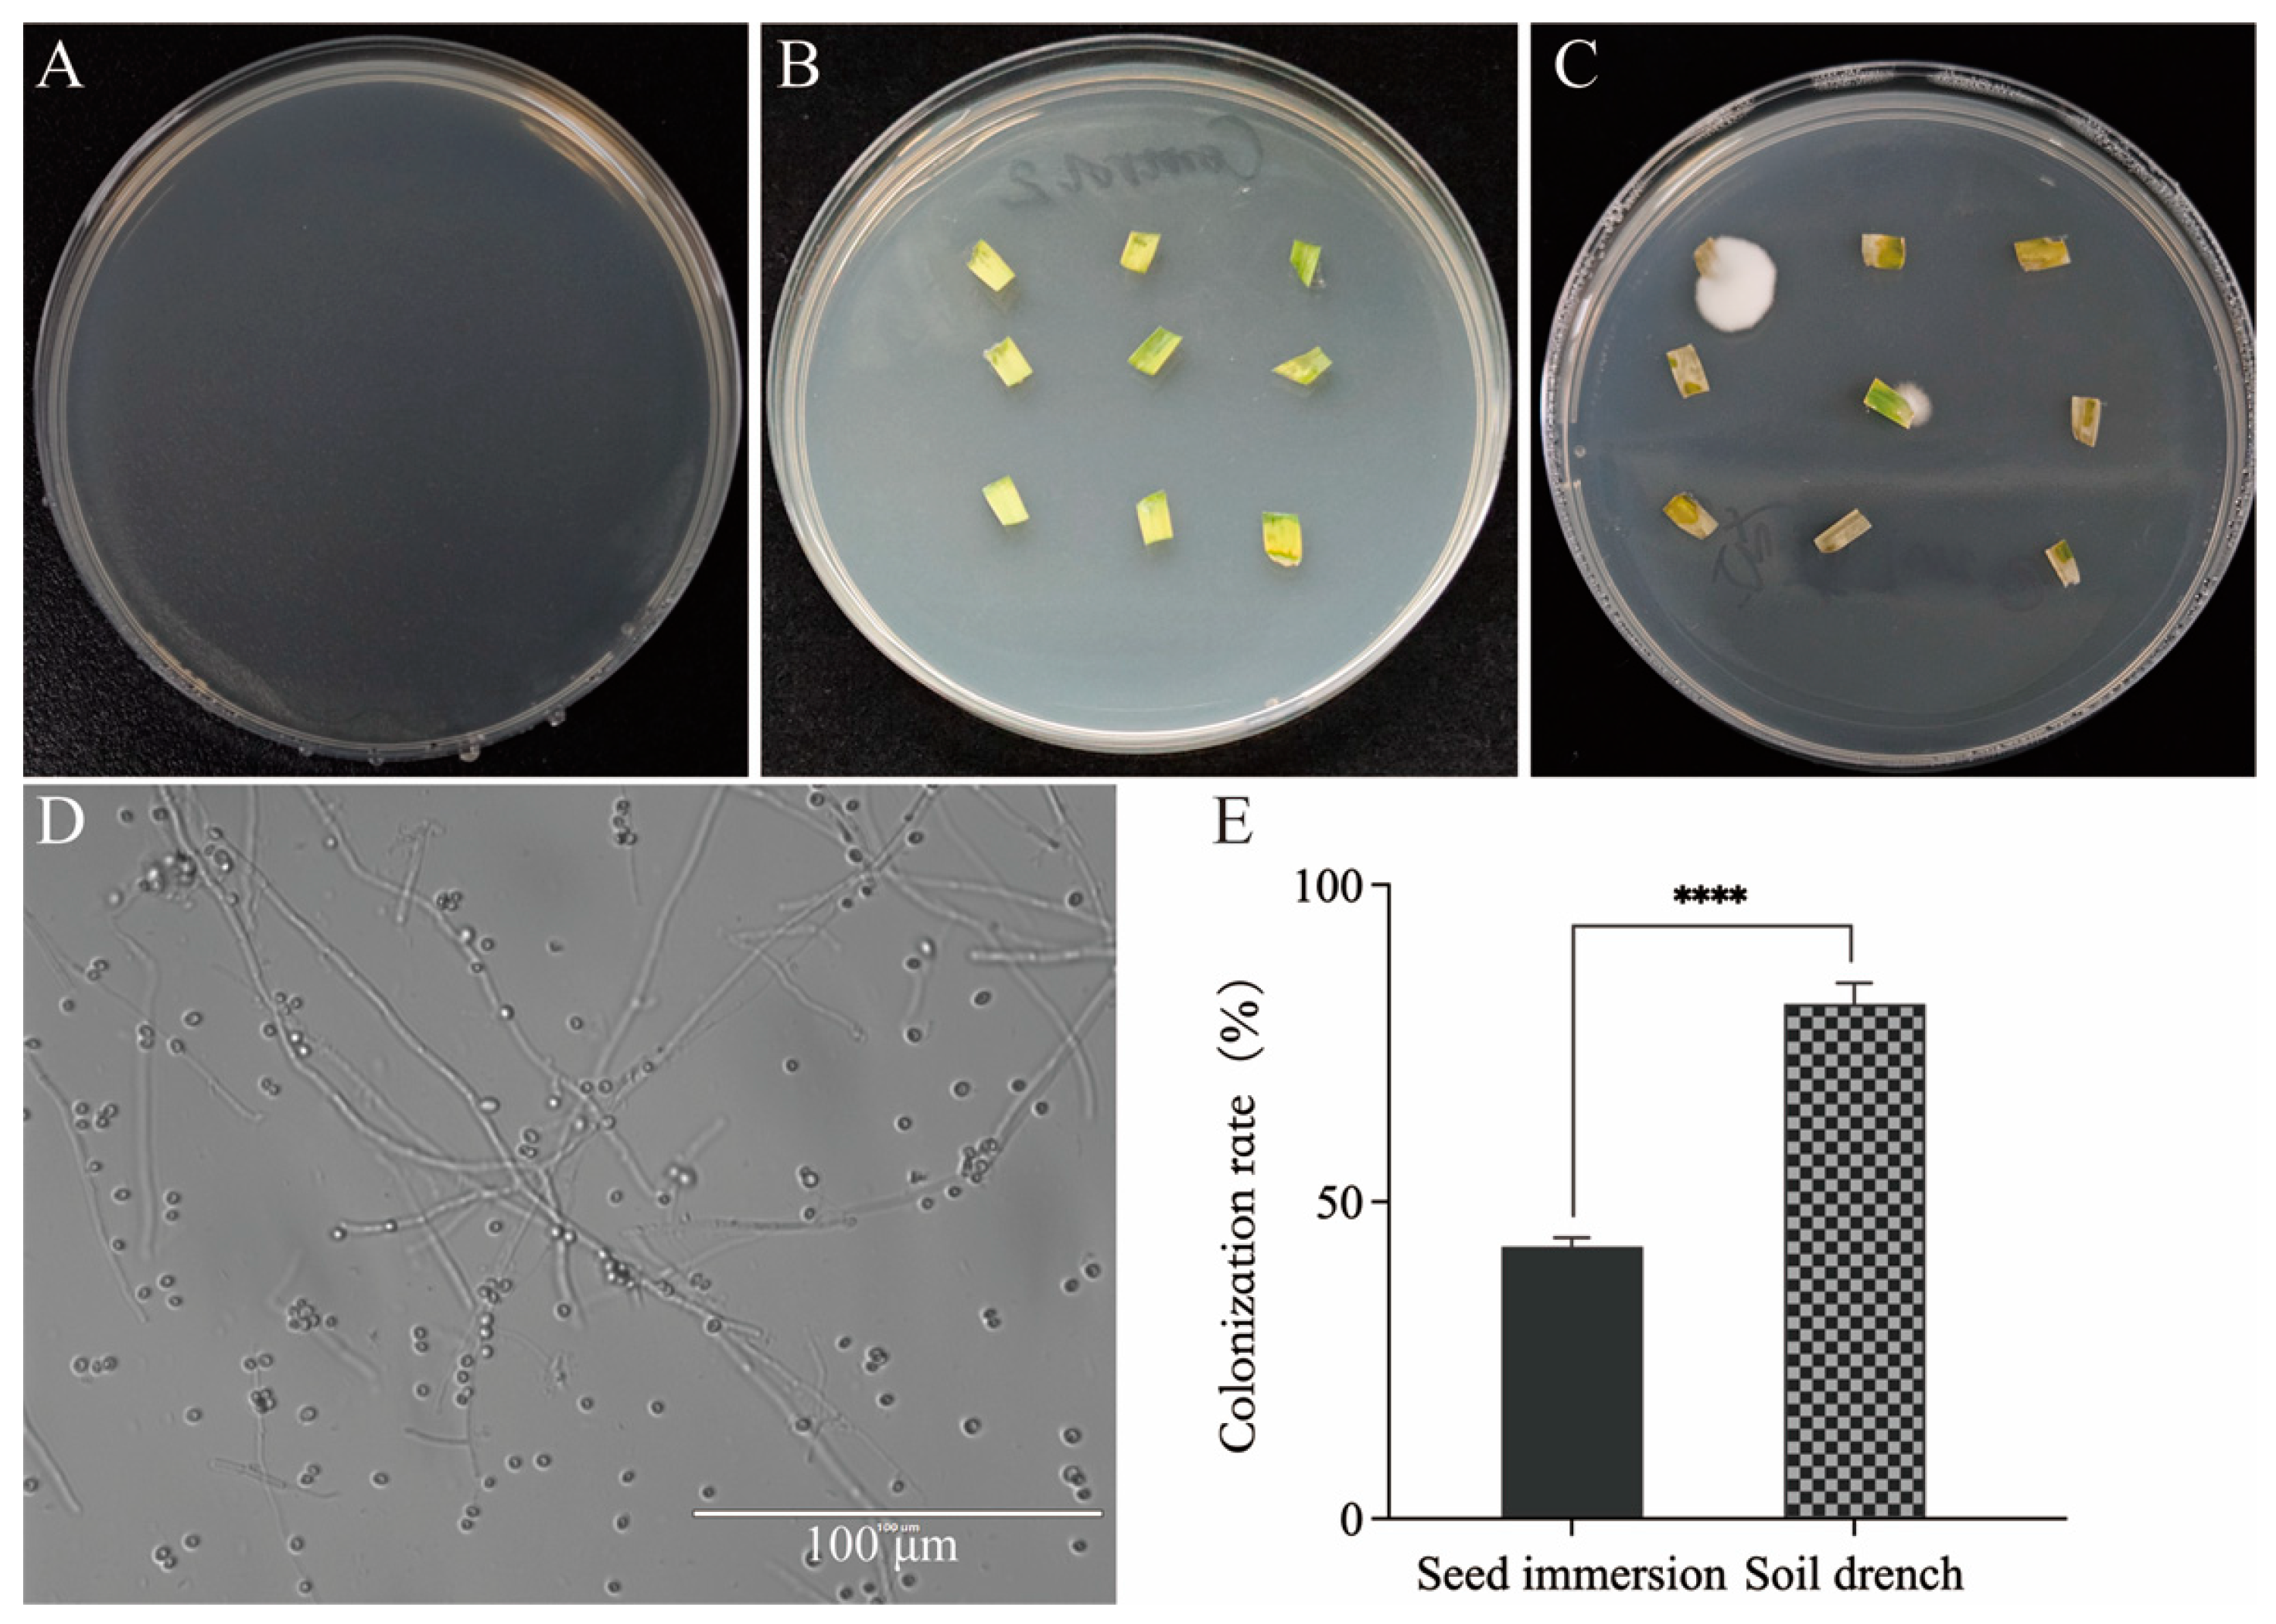

Evaluating Beauveria bassiana Strains for Insect Pest Control and Endophytic Colonization in Wheat
Simple Summary
Abstract
1. Introduction
2. Materials and Methods
2.1. Insects and Fungi
2.2. DNA Extraction, PCR Amplification, and Sequencing
2.3. Insecticidal Activity of Entomopathogenic Fungi
2.3.1. Preparation of Conidial Suspensions
2.3.2. Insecticidal Activity Assay
2.3.3. Calculation of LC50 and LT50
2.4. Entomopathogenic Fungal Colonization of Wheat
2.4.1. Plant Resources and Cultivation Conditions
2.4.2. Seed Immersion Treatment
2.4.3. Soil Drench Treatment
2.4.4. Assessment of Fungal Colonization
2.5. Effect of Fungal Colonization on Plant Growth
2.6. S. frugiperda Feeding with CBM1-Colonized Wheat
2.7. Statistical Analysis
3. Results
3.1. Identification of Three B. bassiana Isolates
3.2. Bioassays of B. bassiana Strains CBM1, CBM2, and CBM3 Against Lepidoptera
3.3. Comparison of the Colonization Rate of B. bassiana CBM1 in Wheat by Seed Immersion and Soil Drenching
3.4. Effect of B. bassiana CBM1 Colonization on Plant Height and Root Length by Soil Drenching
3.5. Effect of Feeding S. frugiperda with B. bassiana CBM1-Colonized Wheat
4. Discussion
Supplementary Materials
Author Contributions
Funding
Data Availability Statement
Conflicts of Interest
References
- Wu, K.M.; Zeng, J.; Wu, Q.L. Research and application of crop pest monitoring and early warning technology in China. Front. Agric. Sci. Eng. 2022, 9, 19–36. [Google Scholar] [CrossRef]
- Wu, K.M.; Guo, Y.Y. The evolution of cotton pest management practices in China. Annu. Rev. Entomol. 2005, 50, 31–52. [Google Scholar] [CrossRef] [PubMed]
- Wu, K. Monitoring and management strategy for Helicoverpa armigera resistance to Bt cotton in China. J. Invertebr. Pathol. 2007, 95, 220–223. [Google Scholar] [CrossRef]
- Xiong, G.H.; Xing, L.S.; Lin, Z.; Saha, T.T.; Wang, C.; Jiang, H.; Zou, Z. High throughput profiling of the cotton bollworm Helicoverpa armigera immunotranscriptome during the fungal and bacterial infections. BMC Genom. 2015, 16, 321. [Google Scholar] [CrossRef]
- Cheng, Y.; Lin, Z.; Wang, J.M.; Xing, L.S.; Xiong, G.H.; Zou, Z. CTL14, a recognition receptor induced in late stage larvae, modulates anti-fungal immunity in cotton bollworm Helicoverpa armigera. Dev. Comp. Immunol. 2018, 84, 142–152. [Google Scholar] [CrossRef]
- Lin, Z.; Wang, J.L.; Cheng, Y.; Wang, J.X.; Zou, Z. Pattern recognition receptors from lepidopteran insects and their biological functions. Dev. Comp. Immunol. 2020, 108, 103688. [Google Scholar] [CrossRef] [PubMed]
- Tang, Y.; Zhang, Y.; Zhang, Q.; Chen, R.; Gong, L.; Wei, X.; Yang, J.; Wu, K.; Huang, W.; Li, S.; et al. Prophenoloxidase-positive tubes derived from the hindguts may be the doorkeeper to detoxify the waste metabolites collected by Malpighian tubules in Lepidoptera insects. Dev. Comp. Immunol. 2022, 131, 104361. [Google Scholar] [CrossRef]
- Cafarchia, C.; Pellegrino, R.; Romano, V.; Friuli, M.; Demitri, C.; Pombi, M.; Benelli, G.; Otranto, D. Delivery and effectiveness of entomopathogenic fungi for mosquito and tick control: Current knowledge and research challenges. Acta Trop. 2022, 234, 106627. [Google Scholar] [CrossRef]
- Almohamad, R.; Hance, T. Encounters with aphid predators or their residues impede searching and oviposition by the aphid parasitoid Aphidius ervi (Hymenoptera: Aphidiinae). Insect Sci. 2014, 21, 181–188. [Google Scholar] [CrossRef]
- Lin, Z.; Cheng, Y.; Wang, R.J.; Du, J.; Volovych, O.; Li, J.C.; Hu, Y.; Lu, Z.Y.; Lu, Z.; Zou, Z. A metalloprotease homolog venom protein from a parasitoid wasp suppresses the Toll pathway in host hemocytes. Front. Immunol. 2018, 9, 2301. [Google Scholar] [CrossRef]
- Lin, Z.; Wang, R.J.; Cheng, Y.; Du, J.; Volovych, O.; Han, L.B.; Li, J.C.; Hu, Y.; Lu, Z.Y.; Lu, Z.; et al. Insights into the venom protein components of Microplitis mediator, an endoparasitoid wasp. Insect Biochem. Mol. Biol. 2019, 105, 33–42. [Google Scholar] [CrossRef]
- Ye, X.; Xiong, S.; Teng, Z.; Yang, Y.; Wang, J.; Yu, K.; Wu, H.; Mei, Y.; Xue, C.; Yan, Z.; et al. Genome of the parasitoid wasp Cotesia chilonis sheds light on amino acid resource exploitation. BMC Biol. 2022, 20, 118. [Google Scholar] [CrossRef] [PubMed]
- Wang, Z.L.; Pan, H.B.; Li, M.Y.; Wu, W.; Yu, X.P. Comprehensive insights into host-pathogen interaction between brown planthopper and a fungal entomopathogen by dual RNA sequencing. Pest Manag. Sci. 2021, 77, 4903–4914. [Google Scholar] [CrossRef]
- Hong, S.; Sun, Y.; Chen, H.; Wang, C. Suppression of the insect cuticular microbiomes by a fungal defensin to facilitate parasite infection. ISME J. 2023, 17, 1–11. [Google Scholar] [CrossRef] [PubMed]
- Wang, L.; Lai, Y.; Chen, J.; Cao, X.; Zheng, W.; Dong, L.; Zheng, Y.; Li, F.; Wei, G.; Wang, S. The ASH1-PEX16 regulatory pathway controls peroxisome biogenesis for appressorium-mediated insect infection by a fungal pathogen. Proc. Natl. Acad. Sci. USA 2023, 120, e2217145120. [Google Scholar] [CrossRef] [PubMed]
- Zhu, X.; Mignon, A.; Nielsen, S.D.; Zieger, S.E.; Koren, K.; Boon, N.; De Belie, N. Viability determination of Bacillus sphaericus after encapsulation in hydrogel for self-healing concrete via microcalorimetry and in situ oxygen concentration measurements. Cem. Concr. Comp. 2021, 119, 104006. [Google Scholar] [CrossRef]
- Xu, Q.; Lin, X.; Gan, L.; Owens, G.; Chen, Z. Green reduction of graphene oxide using Bacillus sphaericus. J. Colloid Interface Sci. 2022, 605, 881–887. [Google Scholar] [CrossRef]
- Pultar, O.; Kocourek, F.; Beránková, J.; Stará, J.; Kuldová, J.; Hrdý, I. Codling Moth management by means of pheromone stations with Cydia Pomonella granulosis virus. Acta Hortic. 2000, 525, 477–480. [Google Scholar] [CrossRef]
- Shapiro, D.I.; Lewis, E.E. Comparison of entomopathogenic nematode infectivity from infected hosts versus aqueous suspension. Environ. Entomol. 1999, 28, 907–911. [Google Scholar] [CrossRef]
- Oliveira-Hofman, C.; Kaplan, F.; Stevens, G.; Lewis, E.; Wu, S.; Alborn, H.T.; Perret-Gentil, A.; Shapiro-Ilan, D.I. Pheromone extracts act as boosters for entomopathogenic nematodes efficacy. J. Invertebr. Pathol. 2019, 164, 38–42. [Google Scholar] [CrossRef]
- Faria, M.R.d.; Wraight, S.P. Mycoinsecticides and Mycoacaricides: A comprehensive list with worldwide coverage and international classification of formulation types. Biol. Control 2007, 43, 237–256. [Google Scholar] [CrossRef]
- Du, J.; Lin, Z.; Volovych, O.; Lu, Z.; Zou, Z. A RhoGAP venom protein from Microplitis mediator suppresses the cellular response of its host Helicoverpa armigera. Dev. Comp. Immunol. 2020, 108, 103675. [Google Scholar] [CrossRef] [PubMed]
- Zeng, S.; Lin, Z.; Yu, X.; Zhang, J.; Zou, Z. Expressing parasitoid venom protein VRF1 in an entomopathogen Beauveria bassiana enhances virulence toward cotton bollworm Helicoverpa armigera. Appl. Environ. Microbiol. 2023, 89, e0070523. [Google Scholar] [CrossRef]
- Hong, S.; Gao, H.; Chen, H.; Wang, C. Engineered fungus containing a caterpillar gene kills insects rapidly by disrupting their ecto- and endo-microbiomes. Commun. Biol. 2024, 7, 955. [Google Scholar] [CrossRef] [PubMed]
- Sánchez-Rodríguez, A.R.; Raya-Díaz, S.; Zamarreño, Á.M.; García-Mina, J.M.; del Campillo, M.C.; Quesada-Moraga, E. An endophytic Beauveria bassiana strain increases spike production in bread and durum wheat plants and effectively controls cotton leafworm (Spodoptera littoralis) larvae. Biol. Control 2018, 116, 90–102. [Google Scholar] [CrossRef]
- Gonzalez-Guzman, A.; Rey, M.D.; Froussart, E.; Quesada-Moraga, E. Elucidating the effect of endophytic entomopathogenic fungi on bread wheat growth through signaling of immune response-related hormones. Appl. Environ. Microbiol. 2022, 88, e0088222. [Google Scholar] [CrossRef]
- Castillo Lopez, D.; Zhu-Salzman, K.; Ek-Ramos, M.J.; Sword, G.A. The entomopathogenic fungal endophytes Purpureocillium lilacinum (formerly Paecilomyces lilacinus) and Beauveria bassiana negatively affect cotton aphid reproduction under both greenhouse and field conditions. PLoS ONE 2014, 9, e103891. [Google Scholar] [CrossRef]
- Sui, L.; Lu, Y.; Zhou, L.; Li, N.; Li, Q.; Zhang, Z. Endophytic Beauveria bassiana promotes plant biomass growth and suppresses pathogen damage by directional recruitment. Front. Microbiol. 2023, 14, 1227269. [Google Scholar] [CrossRef]
- Rivas-Franco, F.; Hampton, J.G.; Narciso, J.; Rostás, M.; Wessman, P.; Saville, D.J.; Jackson, T.A.; Glare, T.R. Effects of a maize root pest and fungal pathogen on entomopathogenic fungal rhizosphere colonization, endophytism and induction of plant hormones. Biol. Control 2020, 150, 104347. [Google Scholar] [CrossRef]
- Dai, J.; Tang, X.; Wu, C.; Liu, S.; Mi, W.; Fang, W. Utilization of plant-derived sugars and lipids are coupled during colonization of rhizoplane and rhizosphere by the fungus Metarhizium robertsii. Fungal Genet. Biol. 2024, 172, 103886. [Google Scholar] [CrossRef]
- Krell, V.; Unger, S.; Jakobs-Schoenwandt, D.; Patel, A.V. Endophytic Metarhizium brunneum mitigates nutrient deficits in potato and improves plant productivity and vitality. Fungal Ecol. 2018, 34, 43–49. [Google Scholar] [CrossRef]
- Qin, X.; Zhao, X.; Huang, S.; Deng, J.; Li, X.; Luo, Z.; Zhang, Y. Pest management via endophytic colonization of tobacco seedlings by the insect fungal pathogen Beauveria bassiana. Pest Manag. Sci. 2021, 77, 2007–2018. [Google Scholar] [CrossRef] [PubMed]
- Mutune, B.; Ekesi, S.; Niassy, S.; Matiru, V.; Bii, C.; Maniania, N.K. Fungal endophytes as promising tools for the management of bean stem maggot Ophiomyia phaseoli on beans Phaseolus vulgaris. J. Pest Sci. 2016, 89, 993–1001. [Google Scholar] [CrossRef]
- Berbegal, M.; Ramon-Albalat, A.; Leon, M.; Armengol, J. Evaluation of long-term protection from nursery to vineyard provided by Trichoderma atroviride SC1 against fungal grapevine trunk pathogens. Pest Manag. Sci. 2020, 76, 967–977. [Google Scholar] [CrossRef]
- Llorens, E.; Sharon, O.; Camanes, G.; Garcia-Agustin, P.; Sharon, A. Endophytes from wild cereals protect wheat plants from drought by alteration of physiological responses of the plants to water stress. Environ. Microbiol. 2019, 21, 3299–3312. [Google Scholar] [CrossRef]
- McMullen, M.; Bergstrom, G.; De Wolf, E.; Dill-Macky, R.; Hershman, D.; Shaner, G.; Van Sanford, D. A unified effort to fight an enemy of wheat and barley: Fusarium head blight. Plant Dis. 2012, 96, 1712–1728. [Google Scholar] [CrossRef]
- Ripa, F.A.; Cao, W.D.; Tong, S.; Sun, J.G. Assessment of plant growth promoting and abiotic stress tolerance properties of wheat endophytic fungi. Biomed Res. Int. 2019, 2019, 6105865. [Google Scholar] [CrossRef]
- Imoulan, A.; Wu, H.J.; Lu, W.L.; Li, Y.; Li, B.B.; Yang, R.H.; Wang, W.J.; Wang, X.L.; Kirk, P.M.; Yao, Y.J. Beauveria medogensis sp. nov., a new fungus of the entomopathogenic genus from China. J. Invertebr. Pathol. 2016, 139, 74–81. [Google Scholar] [CrossRef]
- Kimaru, S.K.; Monda, E.; Cheruiyot, R.C.; Mbaka, J.; Alakonya, A. Morphological and molecular identification of the causal agent of anthracnose disease of Avocado in Kenya. Int. J. Microbiol. 2018, 2018, 4568520. [Google Scholar] [CrossRef]
- Tamura, K.; Dudley, J.; Nei, M.; Kumar, S. MEGA4: Molecular Evolutionary Genetics Analysis (MEGA) software version 4.0. Mol. Biol. Evol. 2007, 24, 1596–1599. [Google Scholar] [CrossRef]
- Posada, F.; Aime, M.C.; Peterson, S.W.; Rehner, S.A.; Vega, F.E. Inoculation of coffee plants with the fungal entomopathogen Beauveria bassiana (Ascomycota: Hypocreales). Mycol. Res. 2007, 111 Pt 6, 748–757. [Google Scholar] [CrossRef] [PubMed]
- Greenfield, M.; Gomez-Jimenez, M.I.; Ortiz, V.; Vega, F.E.; Kramer, M.; Parsa, S. Beauveria bassiana and Metarhizium anisopliae endophytically colonize cassava roots following soil drench inoculation. Biol. Control 2016, 95, 40–48. [Google Scholar] [CrossRef]
- Sani, I.; Jamian, S.; Saad, N.; Abdullah, S.; Mohd Hata, E.; Jalinas, J.; Ismail, S.I. Inoculation and colonization of the entomopathogenic fungi, Isaria javanica and Purpureocillium lilacinum, in tomato plants, and their effect on seedling growth, mortality and adult emergence of Bemisia tabaci (Gennadius). PLoS ONE 2023, 18, e0285666. [Google Scholar] [CrossRef] [PubMed]
- Kaplan, E.L.; Meier, P. Nonparametric estimation from incomplete observations. J. Am. Stat. Assoc. 1958, 53, 457–481. [Google Scholar] [CrossRef]
- Barbarin, A.M.; Bellicanta, G.S.; Osborne, J.A.; Schal, C.; Jenkins, N.E. Susceptibility of insecticide-resistant bed bugs (Cimex lectularius) to infection by fungal biopesticide. Pest Manag. Sci. 2017, 73, 1568–1573. [Google Scholar] [CrossRef] [PubMed]
- Wang, Z.L.; Pan, H.B.; Huang, J.; Yu, X.P. The zinc finger transcription factors Bbctf1alpha and Bbctf1beta regulate the expression of genes involved in lipid degradation and contribute to stress tolerance and virulence in a fungal insect pathogen. Pest Manag. Sci. 2020, 76, 2589–2600. [Google Scholar] [CrossRef]
- Yu, L.; Xu, S.Y.; Tong, S.M.; Ying, S.H.; Feng, M.G. Optional strategies for low-risk and non-risk applications of fungal pesticides to avoid solar ultraviolet damage. Pest Manag. Sci. 2022, 78, 4660–4667. [Google Scholar] [CrossRef]
- Behie, S.W.; Jones, S.J.; Bidochka, M.J. Plant tissue localization of the endophytic insect pathogenic fungi Metarhizium and Beauveria. Fungal Ecol. 2015, 13, 112–119. [Google Scholar] [CrossRef]
- Awan, U.A.; Xia, S.; Meng, L.; Raza, M.F.; Zhang, Z.; Zhang, H. Isolation, characterization, culturing, and formulation of a new Beauveria bassiana fungus against Diaphorina citri. Biol. Control 2021, 158, 104586. [Google Scholar] [CrossRef]
- Vazquez-Benito, J.A.; Santillan-Galicia, M.T.; Guzman-Franco, A.W.; Hernandez-Dominguez, C.; Romero-Rosales, F.; Ortiz-Osuna, A.; Rodriguez-Maciel, J.C. Combined application of predatory mites and fungal pathogens for biological control of Brevipalpus yothersi (Acari: Tenuipalpidae) under laboratory conditions. Biol. Control 2022, 167, 104853. [Google Scholar] [CrossRef]
- Cruz-Avalos, A.M.; Bivian-Hernandez, M.L.A.; Ibarra, J.E.; Del Rincon-Castro, M.C. High virulence of Mexican entomopathogenic fungi against fall armyworm, (Lepidoptera: Noctuidae). J. Econ. Entomol. 2019, 112, 99–107. [Google Scholar] [CrossRef] [PubMed]
- Wang, X.L.; Yang, X.L.; Zhou, F.Y.; Tian, Z.Q.; Cheng, J.; Michaud, J.P.; Liu, X.X. Symbiotic bacteria on the cuticle protect the oriental fruit moth from fungal infection. Biol. Control 2022, 169, 104895. [Google Scholar] [CrossRef]
- Barra-Bucarei, L.; France Iglesias, A.; Gerding Gonzalez, M.; Silva Aguayo, G.; Carrasco-Fernandez, J.; Castro, J.F.; Ortiz Campos, J. Antifungal activity of Beauveria bassiana endophyte against Botrytis cinerea in two solanaceae crops. Microorganisms 2019, 8, 65. [Google Scholar] [CrossRef] [PubMed]
- Nishi, O.; Sushida, H.; Higashi, Y.; Iida, Y. Epiphytic and endophytic colonisation of tomato plants by the entomopathogenic fungus Beauveria bassiana strain GHA. Mycology 2020, 12, 39–47. [Google Scholar] [CrossRef]
- Mantzoukas, S.; Lagogiannis, I.; Mpousia, D.; Ntoukas, A.; Karmakolia, K.; Eliopoulos, P.A.; Poulas, K. Beauveria bassiana endophytic strain as plant growth promoter: The case of the grape vine Vitis vinifera. J. Fungi 2021, 7, 142. [Google Scholar] [CrossRef]
- Jaber, L.R. Seed inoculation with endophytic fungal entomopathogens promotes plant growth and reduces crown and root rot (CRR) caused by Fusarium culmorum in wheat. Planta 2018, 248, 1525–1535. [Google Scholar] [CrossRef]
- Jaber, L.R.; Enkerli, J. Effect of seed treatment duration on growth and colonization of Vicia faba by endophytic Beauveria bassiana and Metarhizium brunneum. Biol. Control 2016, 103, 187–195. [Google Scholar] [CrossRef]
- Akello, J.; Dubois, T.; Coyne, D.; Kyamanywa, S. Endophytic Beauveria bassiana in banana (Musa spp.) reduces banana weevil (Cosmopolites sordidus) fitness and damage. Crop Prot. 2008, 27, 1437–1441. [Google Scholar] [CrossRef]
- Vianna, F.; Pelizza, S.; Russo, L.; Allegrucci, N.; Scorsetti, A. Endophytic Beauveria bassiana (Ascomycota: Hypocreales) alters Helicoverpa gelotopoeon’s (D.) (Lepidoptera: Noctuidae) life cycle and reproductive parameters. J. Plant Prot. Res. 2023, 58, 4. [Google Scholar] [CrossRef]
- Barta, M. In planta bioassay on the effects of endophytic Beauveria strains against larvae of horse-chestnut leaf miner (Cameraria ohridella). Biol. Control 2018, 121, 88–98. [Google Scholar] [CrossRef]
- Fingu-Mabola, J.C.; Bawin, T.; Francis, F. Direct and indirect effect via endophytism of entomopathogenic fungi on the fitness of Myzus persicae and its ability to spread PLRV on tobacco. Insects 2021, 12, 89. [Google Scholar] [CrossRef] [PubMed]
- González-Mas, N.; Valverde-García, R.; Gutiérrez-Sánchez, F.; Quesada-Moraga, E. Effect of passage through the plant on virulence and endophytic behavioural adaptation in the entomopathogenic fungus Beauveria bassiana. Biol. Control 2021, 160, 104687. [Google Scholar] [CrossRef]
- Canassa, F.; Tall, S.; Moral, R.A.; de Lara, I.A.R.; Delalibera, I.; Meyling, N.V. Effects of bean seed treatment by the entomopathogenic fungi and on plant growth, spider mite populations and behavior of predatory mites. Biol. Control 2019, 132, 199–208. [Google Scholar] [CrossRef]
- Camara, I.; Yin, Y.; Cao, K.L.; Sangbaramou, R.; Cao, C.; Tan, S.Q.; Shi, W.P.; Shi, W.P. Effect of antipyretic phenidone on the nodulation response and mortality of locust infected with fungus. Biol. Control 2022, 170, 104933. [Google Scholar] [CrossRef]
- Chou, C.; Hadi, B.A.R.; Chiba, S.; Sato, I.; Choi, I.R.; Tanaka, T. An entomopathogenic fungus and a natural extract benefit rice by suppressing populations of insect pests while keeping high populations of their natural enemies. Biol. Control 2022, 165, 104793. [Google Scholar] [CrossRef]
- Lozano-Tovar, M.D.; Garrido-Jurado, I.; Quesada-Moraga, E.; Raya-Ortega, M.C.; Trapero-Casas, A. Metarhizium brunneum and Beauveria bassiana release secondary metabolites with antagonistic activity against Verticillium dahliae and Phytophthora megasperma olive pathogens. Crop Prot. 2017, 100, 186–195. [Google Scholar] [CrossRef]
- Yun, H.G.; Kim, D.J.; Gwak, W.S.; Shin, T.Y.; Woo, S.D. Entomopathogenic fungi as dual control agents against both the pest Myzus persicae and phytopathogen Botrytis cinerea. Mycobiology 2017, 45, 192–198. [Google Scholar] [CrossRef]
- Deb, L.; Dutta, P. Antagonistic potential of Beauveria bassiana (Balsamo) Vuillemin against Pythium myriotylum causing damping off of tomato. Indian Phytopathol. 2021, 74, 715–728. [Google Scholar] [CrossRef]
- Azadi, N.; Shirzad, A.; Mohammadi, H. A study of some biocontrol mechanisms of Beauveria bassiana against Rhizoctonia disease on tomato. Acta Biol. Szeged. 2016, 60, 119–127. [Google Scholar]

| Concentration | Strains | LT50 (d) (95% Confidence Interval) | |||
|---|---|---|---|---|---|
| P. xylostella | S. frugiperda | H. armigera | M. seperata | ||
| 1 × 108 conidia/mL | CBM1 | 1.29 (0.88–1.63) | 2.21 (1.69–2.69) | 1.31 (0.88–1.67) | 1.92 (0.25–3.12) |
| CBM2 | 2.57 (1.87–3.22) | 3.98 (3.26–4.78) | 3.78 (3.13–4.43) | - | |
| CBM3 | 1.49 (1.05–1.87) | 2.59 (2.01–3.13) | 1.70 (1.11–2.20) | - | |
| 1 × 107 conidia/mL | CBM1 | 2.09 (1.46–2.65) | 2.48 (1.92–3.01) | 1.68 (1.23–2.08) | - |
| CBM2 | 3.41 (2.57–4.38) | 4.91 (4.11–6.13) | 4.87 (4.18–5.82) | - | |
| CBM3 | 3.22 (2.52–3.92) | 2.97 (2.28–3.68) | 2.94 (2.18–3.72) | - | |
| Strains | LC50 (1 × 105 Conidia/mL) (95% Confidence Interval) | |||
|---|---|---|---|---|
| P. xylostella | S. frugiperda | H. armigera | M. seperata | |
| CBM1 | 14.76 (0.03–58.67) | 10.06 (0.11–39.71) | 8.53 (0.21–36.34) | 126.84 |
| CBM2 | 47.82 (0.01–273.88) | 52.10 (0.33–251.07) | 39.17 (0.66–196.46) | - |
| CBM3 | 17.13 (0.03–67.87) | 16.17 (0.19–66.59) | 13.52 (0.313–61.99) | - |
Disclaimer/Publisher’s Note: The statements, opinions and data contained in all publications are solely those of the individual author(s) and contributor(s) and not of MDPI and/or the editor(s). MDPI and/or the editor(s) disclaim responsibility for any injury to people or property resulting from any ideas, methods, instructions or products referred to in the content. |
© 2025 by the authors. Licensee MDPI, Basel, Switzerland. This article is an open access article distributed under the terms and conditions of the Creative Commons Attribution (CC BY) license (https://creativecommons.org/licenses/by/4.0/).
Share and Cite
Liu, L.; Liu, S.; Meng, Q.; Chen, B.; Zhang, J.; Zhang, X.; Lin, Z.; Zou, Z. Evaluating Beauveria bassiana Strains for Insect Pest Control and Endophytic Colonization in Wheat. Insects 2025, 16, 287. https://doi.org/10.3390/insects16030287
Liu L, Liu S, Meng Q, Chen B, Zhang J, Zhang X, Lin Z, Zou Z. Evaluating Beauveria bassiana Strains for Insect Pest Control and Endophytic Colonization in Wheat. Insects. 2025; 16(3):287. https://doi.org/10.3390/insects16030287
Chicago/Turabian StyleLiu, Lulu, Shiming Liu, Qingfan Meng, Bing Chen, Junjie Zhang, Xue Zhang, Zhe Lin, and Zhen Zou. 2025. "Evaluating Beauveria bassiana Strains for Insect Pest Control and Endophytic Colonization in Wheat" Insects 16, no. 3: 287. https://doi.org/10.3390/insects16030287
APA StyleLiu, L., Liu, S., Meng, Q., Chen, B., Zhang, J., Zhang, X., Lin, Z., & Zou, Z. (2025). Evaluating Beauveria bassiana Strains for Insect Pest Control and Endophytic Colonization in Wheat. Insects, 16(3), 287. https://doi.org/10.3390/insects16030287

